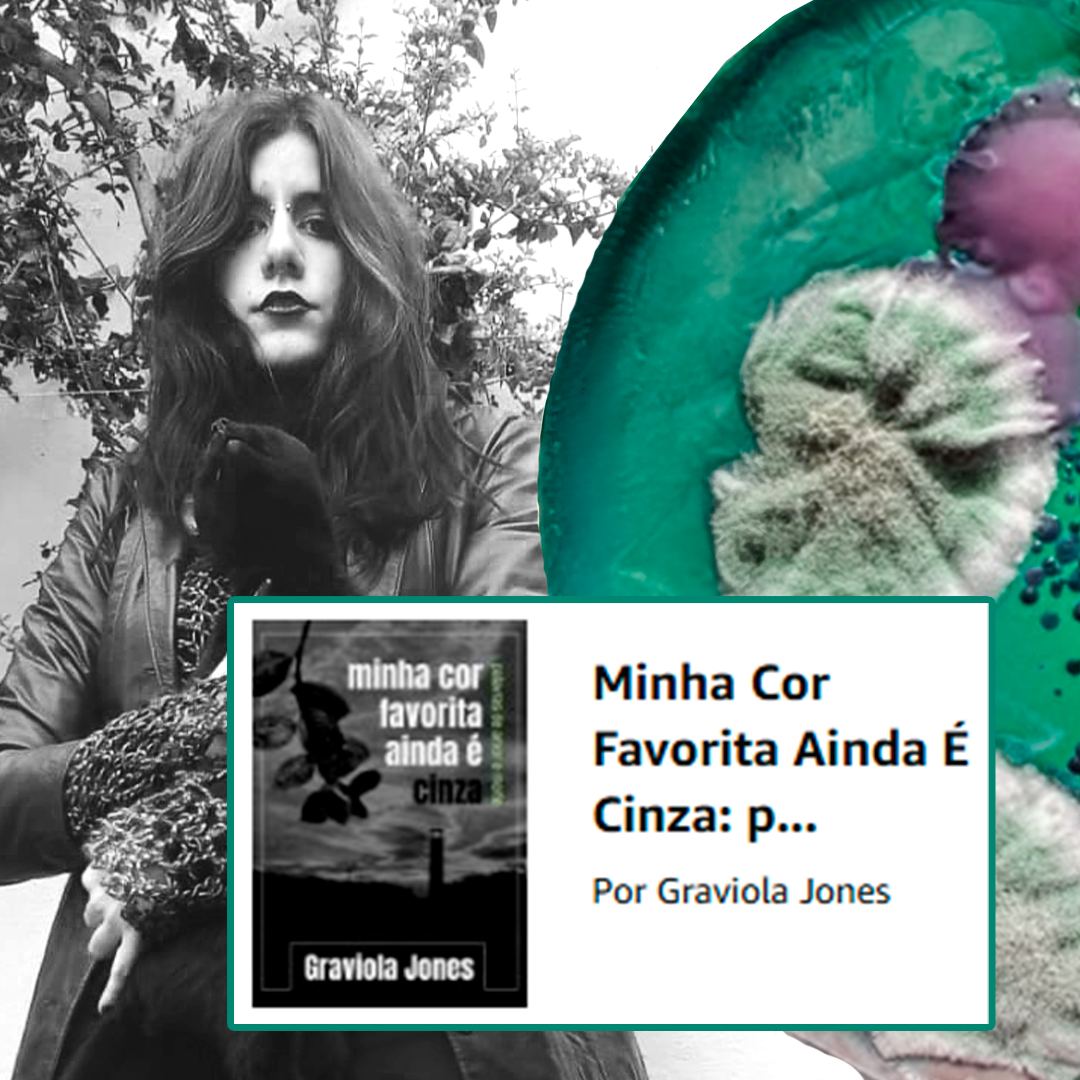
Livro Minha Cor Favorita Ainda É Cinza

Gabriela Malato (vulgo Graviola Jones) é uma poetisa, musicista e artista multimídia habitante da zona leste de São Paulo. Com forte influência da subcultura gótica em suas obras, costuma retratar temas que se relacionem com a finitude da vida “memento mori”, amor e dor, música, e principalmente, natureza: seja humana, flora ou fauna. Explora diferentes linguagens visuais e materiais, atravessando imagem, matéria e palavra, investigando símbolos, memória e processos artesanais.